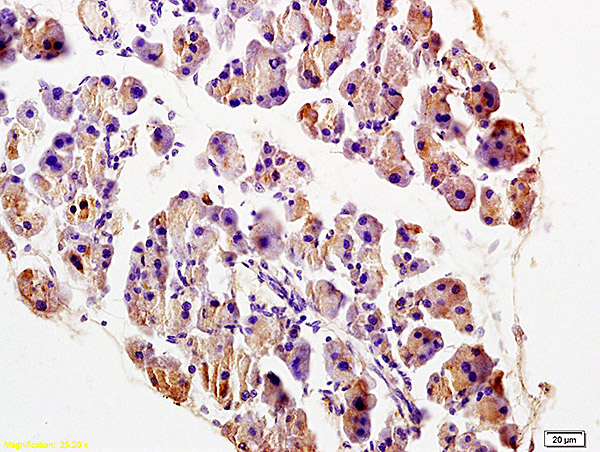
Formalin-fixed and paraffin embedded rat pancreas labeled with Anti-TRADD Polyclonal Antibody, Unconjugated (bs-1202R) at 1:200 followed by conjugation to the secondary antibody and DAB staining. Formalin-fixed and paraffin embedded rat pancreas labeled with Anti-TRADD Polyclonal Antibody, Unconjugated (bs-1202R) at 1:200 followed by conjugation to the secondary antibody and DAB staining.

Lane 1: human colon carcinoma lysate; Lane 2: rat brain lysate probed with TRADD Polyclonal Antibody, Unconjugated (bs-1202R) at 1:200 overnight at 4˚C. Followed by conjugation to secondary antibody (bs-0295G-HRP) at 1:3000 for 90 min at 37˚C.
TRADD Polyclonal Antibody
BS-1202R
ApplicationsImmunoFluorescence, Western Blot, ELISA, ImmunoCytoChemistry, ImmunoHistoChemistry, ImmunoHistoChemistry Frozen, ImmunoHistoChemistry Paraffin
Product group Antibodies
ReactivityHuman, Mouse, Rat
TargetTradd
Overview
- SupplierBioss
- Product NameTRADD Polyclonal Antibody
- Delivery Days Customer16
- ApplicationsImmunoFluorescence, Western Blot, ELISA, ImmunoCytoChemistry, ImmunoHistoChemistry, ImmunoHistoChemistry Frozen, ImmunoHistoChemistry Paraffin
- Applications SupplierWB(1:300-5000), ELISA(1:500-1000), IHC-P(1:200-400), IHC-F(1:100-500), IF(IHC-P)(1:50-200), IF(IHC-F)(1:50-200), IF(ICC)(1:50-200)
- CertificationResearch Use Only
- ClonalityPolyclonal
- Concentration1 ug/ul
- ConjugateUnconjugated
- Gene ID71609
- Target nameTradd
- Target descriptionTNFRSF1A-associated via death domain
- Target synonyms9130005N23Rik, tumor necrosis factor receptor type 1-associated DEATH domain protein, TNF receptor 1 associated signal transducer, TNFR1-associated DEATH domain protein
- HostRabbit
- IsotypeIgG
- Protein IDQ3U0V2
- Protein NameTumor necrosis factor receptor type 1-associated DEATH domain protein
- ReactivityHuman, Mouse, Rat
- Storage Instruction-20°C
- UNSPSC12352203
References
- Chen Z, Zhang Z, Zhang D, et al. Hydrogen sulfide protects against TNF-α induced neuronal cell apoptosis through miR-485-5p/TRADD signaling. Biochem Biophys Res Commun. 2016,478(3):1304-9. doi: 10.1016/j.bbrc.2016.08.116Read this paper